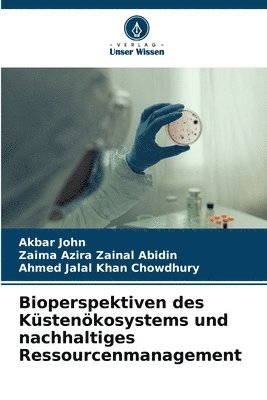

Akbar John – författare
2 106 kr
Skickas inom 10-15 vardagar
823 kr
Kommande
909 kr
Läs direkt efter köp
Sustainable Management of Urban Plastic Waste Through Circular Economic Approaches covers the technologies and methods essential to overcome single-use plastic processing waste. It describes the biotechnological methods, cutting-edge research, procedures, and applications required to safeguard global sustainable development along with plastic waste management.
This book:
Describes technological advances made towards remediation and valorization technologies of plastic pollutants to reduce microplastic pollution Focuses on accelerating using single-use plastic waste in value-added products Includes examples and case studies of impact and treatment of plastics in the circular economy Explains the socio-economic benefits of reducing plastic pollutionThis book will be of interest to researchers, scientists, and engineers working on sustainable management of plastic waste, especially in the chemical and environmental engineering and biotechnology sectors.
909 kr
Läs direkt efter köp
Sustainable Management of Urban Plastic Waste Through Circular Economic Approaches covers the technologies and methods essential to overcome single-use plastic processing waste. It describes the biotechnological methods, cutting-edge research, procedures, and applications required to safeguard global sustainable development along with plastic waste management.
This book:
Describes technological advances made towards remediation and valorization technologies of plastic pollutants to reduce microplastic pollution Focuses on accelerating using single-use plastic waste in value-added products Includes examples and case studies of impact and treatment of plastics in the circular economy Explains the socio-economic benefits of reducing plastic pollutionThis book will be of interest to researchers, scientists, and engineers working on sustainable management of plastic waste, especially in the chemical and environmental engineering and biotechnology sectors.
2 308 kr
Kommande
362 kr
Skickas inom 5-8 vardagar
362 kr
Skickas inom 5-8 vardagar
362 kr
Skickas inom 5-8 vardagar
339 kr
Skickas inom 5-8 vardagar
339 kr
Skickas inom 5-8 vardagar
339 kr
Skickas inom 5-8 vardagar